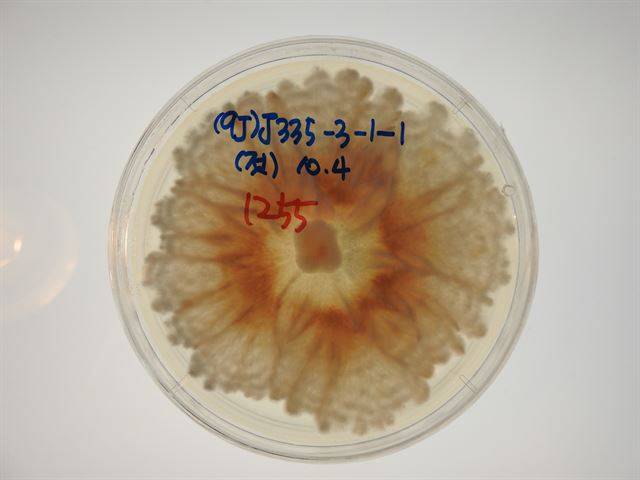
잎이나 줄기 속에 사는 내생균은 그 종류도 다양하고 같은 종이라도 숙주생물이 어떤 형태인지에 따라 그 모습과 상호작용이 달라진다. 샬레에 내생균을 배양한 모습. 국립생태원 제공

[아하! 생태!] 생물에 붙어살며 키우고 지키는 곰팡이

어렸을 적 일요일 아침이면 부모님과 함께 ‘한 지붕 세 가족’이라는 드라마를 보기 위해 졸린 눈을 비비면서 TV 앞에 앉아 있었던 기억이 납니다. 한 집에서 살아가는 이웃들이 갈등하고 화해하는 평범한 일상을 시트콤 형식으로 표현해서 재미있게 봤었죠.
자연계에서도 여러 가족이 함께 살아가는 상황을 자주 발견할 수 있습니다. 특히 식물은 눈에 보이지는 않지만 잎과 뿌리 속에 여러 곰팡이가 살면서 성장에 도움을 주는데요. 이런 긍정적인 상호작용을 하는 곰팡이를 우리는 ‘공생균(共生菌ㆍSymbiotic fungi)’이라고 부릅니다.
공생균은 다른 생물과 더불어 공생하며 살아가는 진균(곰팡이)을 통칭하는 말입니다. 사실 균이라고 하면 이미지가 썩 좋지는 않을 거에요. 보통은 세균을 먼저 떠올리면서 자연스레 어릴 때 감기 때문에 병원 신세를 진 경험을 생각하게 되거든요. 하지만 진균과 세균은 엄연히 다릅니다. 자세히 관찰해보면 진균은 세포벽이 있는 반면 세균은 세포벽이 없거든요. 대표적인 진균은 팽이버섯이나 술을 발효시키는 효모, 세균은 대장균을 들 수 있습니다.
생물과 함께 사는 진균도 공생균 외에 여러 종류가 있습니다. 먼저 동물의 사체나 식물의 잔해를 분해하는 ‘부생균’이 있고, 동물이나 식물에 병을 일으키는 ‘병원균’도 있죠.
잎과 뿌리에 사는 공생균
공생균 속으로 좀 더 들어가 보면 잎이나 줄기 등에 공생하는 부류와 뿌리에 공생하는 부류로 구분할 수 있습니다. 또 뿌리에 공생하는 부류는 다시 뿌리의 외부 표면을 감싸는 형태와 뿌리의 내부에 침투하는 형태가 있습니다.
‘내생균(內生菌, Endophytic fungi)’은 잎이나 줄기에 살면서 병을 일으키지 않는 균을 말합니다. 이들은 지구상의 모든 식물에 존재하며 각각의 식물들과 다양한 관계를 맺습니다. 주로 오래된 빵이나 귤에서 발견할 수 있는 ‘자낭균’과 버섯을 만드는 ‘담자균’을 들 수 있는데요. 자낭균의 비율이 압도적으로 높다고 하네요. 모든 식물에 있는 만큼 그 종류도 다양하고 분포 형태도 다양합니다. 특정한 지역에서만 발견되는 종이 있는 반면 전 세계적으로 분포하는 종류도 있습니다. 숙주가 되는 식물에 따라서도 내생균의 종류가 달라지기 때문에 다양한 분야에서 연구가 이뤄지고 있죠.

뿌리 속에 사는 공생균은 ‘수지상균근균(樹枝狀菌根菌ㆍarbuscular mycorrhizal fungi)’이라고하는데요. 보통은 줄여서 수지상균이라고 부릅니다. 수지상균은 전 세계적으로 200여종 밖에 없지만 지구상 대부분의 식물과 공생 관계를 맺습니다. 이런 일이 가능한 것은 수지상균이 갖고 있는 ‘다유전체’라는 매우 독특한 유전체 구조 때문인데요. 수지상균은 한 개의 작은 포자에 600~3,000개의 유전체를 갖고 있습니다. 사람으로 치면 그 만큼의 군중이 한 공간에 모여있는 것과 마찬가지인데요. 그만큼 수지상균이 가진 각각의 포자 자체가 다양성을 가지고 있기 때문에 숙주 식물에 따라서 다양한 상호작용이 가능한 것입니다.
뿌리 밖에 살면서 식물과 공생한다는 의미의 이름을 가진 ‘외생균근균(外生菌根菌ㆍEoctomycorrhizal fungi)’도 흔히들 외생균이라고 부릅니다. 식물의 뿌리를 외생균의 균사가 감싸는 형태로 사는데요. 그렇기 때문에 딱딱하게 목질화된 굵은 뿌리 대신 뿌리 끝부분에 실처럼 부드럽게 자라나는 뿌리털에서 식물과 균이 만나는 ‘균근’이 형성됩니다. 나무에서 자라는 송이나 능이 같은 버섯류가 우리에게 친숙한 외생균이죠.

공생균이 식물과 함께 살아가는 전략
공생균들은 식물과 공생하기 위해 각자 조금씩 다른 전략을 취합니다.
내생균들이 식물과 공생하는 방법은 우선 아무도 침범하지 않은 식물체의 일부분을 점유하는 방식을 들 수 있습니다. 이미 균이 살고 있는 식물이기 때문에 병원균이 들어올 자리가 사라지게 되죠. 식물체에 들어간 내생균은 항생 물질을 만들어내기도 하는데요. 이렇게 만들어진 항생물질은 식물에 침입하려는 병원균을 억제하거나 제거하는 역할을 합니다. 미생물이 식물에 영양소를 공급하는 ‘2차대사’도 내생균이 담당하는데요. 내생균이 생산하는 2차대사산물은 식물의 숨구멍(기공)을 열고 닫는 등 숙주식물의 생리를 조절합니다.
수지상균과 외생균은 내생균과는 다른 방식으로 공생합니다. 이 두 종류의 균은 뿌리 세포의 내부나 외부를 감싸 식물 세포와의 접점을 만들고 이를 통해 양분을 교환합니다. 식물은 포도당 같은 광합성을 통해 만들어진 산물을 공생균에 제공하고 공생균은 식물의 뿌리가 직접 흡수하기 어려운 인과 같은 무기양분을 식물에게 줍니다.
대부분의 공생균은 식물의 생장에 긍정적으로 관여하고 그에 대해 서식처나 양분을 제공받습니다. 식물의 건강에는 반드시 공생균이 관여하죠. 굳이 비유하자면 인간의 장 속에 있는 건강한 미생물이 소화를 돕는 것과 비슷하다고나 할까요.

눈에 보이지 않지만 없어서는 안될 존재, 곰팡이
진균은 지구의 역사 초기부터, 식물보다도 먼저 존재했다고 합니다. 진균이 태어난 것은 약 7억~10억년 전, 식물은 4억7,000만년 전에 태어났거든요. 그런 면에서 지구상에 존재하는 생명체들은 진균과 함께 해왔다고 할 수 있겠죠. 균류가 없었다면 숲도 초원도 없었을지 모르고, 초식동물도 그리고 그 초식동물의 배설물도 없었을 것이다. 상상도 하기 싫지만 모든 동ㆍ식물의 잔해들이 썩지 않고 그대로 남아 있었을 수도 있겠네요. 균류는 약 150만종 가량 존재하는 것으로 추정되는데요. 하늘이든 땅이든 바다든 이 세계의 어디에서나 생태계의 주요 구성요소로 자리잡고 있습니다.
국립생태원에서는 식물과 공생균의 다양한 관계 중에서도 침엽수에 대한 연구를 진행하고 있습니다. 지구상에 30만여 종이나 되는 식물 중에 왜 하필 침엽수 일까요. 식물의 무리 중 가장 적은 종류의 무리가 바로 침엽수이기 때문이죠. 변종 등을 포함해도 600여종밖에 안됩니다.
침엽수는 환경 변화에도 가장 취약한 무리죠. 최근에는 가슴 아프게도 기후변화나 산림 쇠퇴 현상에 의해서 급속하게 사라져 가고 있거든요. 구상나무나 분비나무 같은 침엽수가 집단으로 고사하고 있다는 뉴스는 이미 여러 차례 나왔죠.
물론 이들을 되살리기 위한 노력도 다방면으로 이뤄지고 있습니다. 하지만 지금까지의 수많은 노력은 복원이라기보다는 조림(나무심기)의 그늘에 가려져 있었던 게 아닌가 하는 생각이 듭니다.
생태계는 복잡한 그물과 같습니다. 우리가 생태계를 복원 할 때 고려해야 할 많은 연결고리가 있다는 의미입니다. 이러한 연결고리들을 고려한 생태적 복원이 필요하며, 침엽수 복원에서 공생균에 대한 연구는 인간에 의해 파괴된 생태계라는 그물코의 한 부분을 수선하는 과정일 것입니다. 공기가 눈에 보이지는 않아도 지구상의 생명을 지탱하는 것처럼 공생균도 식물에게는 보이지는 않지만 생존에 중요한 존재들 중의 하나입니다.
사람들은 반달가슴곰이나 한라산 구상나무처럼 눈에 보이는 동ㆍ식물이 사라지는 것을 매우 관심 있게 지켜보며 보호하려 합니다. 하지만 구상나무의 진화 과정과 역사를 공유하는 공생균이 사라지는 것에 대해서는 매우 둔감하죠. 식물과 함께 살아 온 공생균의 역사를 지키는 것도 눈에는 보이지는 않지만 노력할만한 가치가 있는 중요한 일이 아닐까요.
이제까지 우리는 생태계에 대해서 거시적인 관점에서 접근을 해 왔지만 이제는 생물 하나하나와 그에 따른 연결고리를 연구하는 미시적인 관점을 함께 가지고 바라봐야 하는 것 아닐까 하는 생각이 듭니다. 생태학적 원리에 기반한 생물다양성의 규명이야말로 우리가 추구해야 할 목표라고 할 수 있죠. 그런 측면에서 공생균에 대한 연구는 우리에게 식물 뿐이 아니라 생태계 전반을 아우르는, 한 단계 나아간 시각을 제공해 주는 것이 아닐까 합니다.
어주경 국립생태원 생태기반연구실 연구원
Copyright © 한국일보. 무단전재 및 재배포 금지.